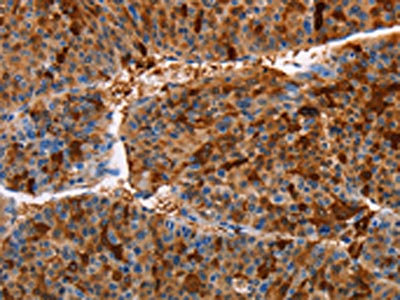

AKR1B10 Antibody
-
中文名稱:AKR1B10兔多克隆抗體
-
貨號(hào):CSB-PA918257
-
規(guī)格:¥1100
-
圖片:
-
The image on the left is immunohistochemistry of paraffin-embedded Human liver cancer tissue using CSB-PA918257(AKR1B10 Antibody) at dilution 1/30, on the right is treated with fusion protein. (Original magnification: ×200)
-
The image on the left is immunohistochemistry of paraffin-embedded Human lung cancer tissue using CSB-PA918257(AKR1B10 Antibody) at dilution 1/30, on the right is treated with fusion protein. (Original magnification: ×200)
-
Gel: 10%SDS-PAGE, Lysate: 40 μg, Lane: A549 cells, Primary antibody: CSB-PA918257(AKR1B10 Antibody) at dilution 1/184, Secondary antibody: Goat anti rabbit IgG at 1/8000 dilution, Exposure time: 5 seconds
-
-
其他:
產(chǎn)品詳情
-
Uniprot No.:
-
基因名:
-
別名:AK1BA_HUMAN antibody; AKR1B10 antibody; AKR1B11 antibody; AKR1B12 antibody; Aldo keto reductase family 1 member B10 antibody; aldo keto reductase family 1 member B11 antibody; Aldo-keto reductase family 1 member B10 (aldose reductase) antibody; Aldo-keto reductase family 1 member B10 antibody; Aldo-keto reductase family 1 member B11 (aldose reductase-like) antibody; aldose reductase like 1 antibody; Aldose reductase like antibody; aldose reductase like peptide antibody; Aldose reductase related protein antibody; Aldose reductase-like antibody; Aldose reductase-related protein antibody; ALDRLn antibody; ARL 1 antibody; ARL-1 antibody; ARL1 antibody; ARL1 Human small intestine reductase antibody; ARP antibody; hARP antibody; HIS antibody; HSI antibody; SI reductase antibody; Small intestine reductase antibody
-
宿主:Rabbit
-
反應(yīng)種屬:Human
-
免疫原:Fusion protein of Human AKR1B10
-
免疫原種屬:Homo sapiens (Human)
-
標(biāo)記方式:Non-conjugated
-
抗體亞型:IgG
-
純化方式:Antigen affinity purification
-
濃度:It differs from different batches. Please contact us to confirm it.
-
保存緩沖液:-20°C, pH7.4 PBS, 0.05% NaN3, 40% Glycerol
-
產(chǎn)品提供形式:Liquid
-
應(yīng)用范圍:ELISA,WB,IHC
-
推薦稀釋比:
Application Recommended Dilution ELISA 1:2000-1:5000 WB 1:200-1:1000 IHC 1:25-1:100 -
Protocols:
-
儲(chǔ)存條件:Upon receipt, store at -20°C or -80°C. Avoid repeated freeze.
-
貨期:Basically, we can dispatch the products out in 1-3 working days after receiving your orders. Delivery time maybe differs from different purchasing way or location, please kindly consult your local distributors for specific delivery time.
-
用途:For Research Use Only. Not for use in diagnostic or therapeutic procedures.
相關(guān)產(chǎn)品
靶點(diǎn)詳情
-
功能:Catalyzes the NADPH-dependent reduction of a wide variety of carbonyl-containing compounds to their corresponding alcohols. Displays strong enzymatic activity toward all-trans-retinal, 9-cis-retinal, and 13-cis-retinal. Plays a critical role in detoxifying dietary and lipid-derived unsaturated carbonyls, such as crotonaldehyde, 4-hydroxynonenal, trans-2-hexenal, trans-2,4-hexadienal and their glutathione-conjugates carbonyls (GS-carbonyls). Displays no reductase activity towards glucose.
-
基因功能參考文獻(xiàn):
- Immunohistochemistry showed that the expression of AKR1B10 was increased in tumor tissue from patients with early-stage HCC. PMID: 30328412
- These results suggest that AKR1B10 is involved in HBV-related hepatocarcinogenesis, but its high expression could predict low risk of early tumor recurrence in patients with HBV-related hepatocellular carcinoma (HCC)after liver resection. PMID: 28181486
- AKR1B10 is upregulated in mucinous cystic pancreatic tumors and may be used to improve non-operative diagnosis. PMID: 29079172
- A combined gene expression signature of AKR1B10 (low) and AKR1B1 (high) showed a better prognostic stratification of CRC patients independent of confounding factors. PMID: 28929377
- Our study demonstrated not only the dysfunction of the AKR1B10 gene in lipid metabolizing but also its important role in the overproliferation and migration of keratinocyte, which provided evidence for further therapeutic uses for psoriasis. PMID: 29204449
- Data show that cells with higher levels of aldo-keto reductases AKR1B1 and/or AKR1B10 (AKR1Bs) were more sensitive to 2-deoxyglucose (2DG). PMID: 29617059
- Results demonstrate that Akr7a3 mRNA and protein levels are consistently co-expressed along with Akr1b10, in both experimental rat liver carcinogenesis and some human hepatocellular carcinoma samples. PMID: 29383608
- AKR1B10 overexpression is an independent poor prognostic biomarker for oral squamous cell carcinoma. PMID: 28301069
- These data suggest that AKR1B10 promotes breast cancer metastasis PMID: 27248472
- Several antioxidant response elements-like sequences in the 5'-flanking region up to -3282 bp of the AKR1B10 gene plays an important role in AKR1B10 gene regulation by various Nrf2-mediating stimuli. PMID: 28219640
- This study presents novel evidence that AKR1B10 protects colon cells from DNA damage induced by electrophilic carbonyl compounds. PMID: 26969882
- the highly efficient, retinaldehyde-specific aldo-keto reductase enzyme AKR1B10 is up-regulated in keloid epidermis(KE) and its induced overexpression in normal skin keratinocytes affects the classical RA pathway, recreating KE expression patterns PMID: 27025872
- Data suggest that expression of STAR (steroidogenic acute regulatory protein) and AKR1B10 (aldo-keto reductase family 1, member B10) is down-regulated in high-grade versus low-grade endometrial tumors; expression of AKR1B10 correlates with body mass index, with up-regulation of expression of AKR1B10 in obese patients with endometrial tumors. PMID: 28232277
- Result indicate that the differential scanning fluorimetry (DSF) method is useful for enzyme inhibitor drug screening for the AKR superfamily, including AKR1B10 and a structurally similar isoform AKR1B1. PMID: 28003428
- Chronic hepatitis C patients expressing high levels of hepatic AKR1B10 had an increased risk of HCC development even after sustained virological response PMID: 27672277
- Various degrees of AKR1B10 upregulation in the liver were observed in patients with chronic HCV infection, and high AKR1B10 expression could be a novel pre- dictor of HCC. PMID: 26758591
- AKR1B10 is up-regulated with cisplatin resistance in gastrointestinal cancer cells. PMID: 27417252
- AKR1B10 mRNA and protein levels were higher in primary hepatocellular carcinoma (PHC) tissues than in peri-tumor tissues. PMID: 26948042
- AKR1B10 is overexpressed in nasopharyngeal hyperplasia, benign tumors, and carcinomas, being a potential new biomarker. PMID: 26835713
- Even at early stages of malignant transformationa considerable increase in AKR1B10 mRNA content was observed in 80% of tumors PMID: 27239845
- It would appear that hepatitis C virus infection alone increases AKR1B10 expression, which manifests itself as enhanced urinary excretion of polyols with reduced urinary excretion of their corresponding hexoses. PMID: 25487531
- Our data suggest that genetic variants in the AKR1B10 locus may influence human eating behavior. PMID: 25887478
- The three-dimensional structure of AKR1B10 with sulindac. PMID: 25532697
- The co-introduction of the c-Jun protein resulted in a decrease in the mRNA levels and promoter activity of AKR1B10. PMID: 25463304
- Autophagy and AKR1B10 contribute to the defense system. PMID: 25289770
- AKR1B10 is a doxorubicin-resistance gene in the gastric cancer cells, and is responsible for elevating the migrating and invasive potentials of the cells through induction of MMP2. PMID: 25686905
- Upregulation of AKR1B10 is associated with cisplatin resistance in lung cancer. PMID: 25156503
- AKR1B10 is a unique enzyme involved in pancreatic carcinogenesis via modulation of the Kras-E-cadherin pathway. PMID: 25304374
- AKR1B10 may have an important role in the development and progression of diabetic nephropathy. PMID: 23975544
- A significant correlation between the expression of AKR1B10 mRNA and protein levels as well as AKR1B10 copy number was observered, which suggest that AKR1B10 may play a role in AFB1-related hepatocarcinogenesis. PMID: 24391771
- Results suggest that decreased expression of AKR1B10 could disrupt the tumor suppressive function of p53, which result in decreased survival in colorectal cancer patients. PMID: 24140838
- AKR1B10, a member of Aldo-keto reductase family, was shown to be abundantly located in the filtering cells among a catalog of proteins.in ducal carcinoma of the breast. PMID: 23912490
- AKR1B10 is a unique biomarker involved in hepatocellular carcinogenesis PMID: 24656094
- AKR1B10 protein gene expression is a valuable indicator in patients diagnosed with gastric cancer. PMID: 24406159
- Lys-233, Glu-236, and Lys-240 in helix 10 mediate interaction of AKR1B10 with HSP90alpha and regulate AKR1B10 secretion. PMID: 24217247
- A hydrogen bond stabilized active site tryptophan conformation restricts inhibitor access in AKR1B1 compared with the more open AKR1B10 active site. PMID: 24100137
- our data suggest that post-chemotherapy AKR1B10 expression may be associated with a poor prognosis in patients who received carboplatin-gemcitabine combination chemotherapy and underwent cystectomy PMID: 22198799
- The gene expression of AKR1B10 at the mRNA level was significantly increased. PMID: 23146748
- AKR1B10 was the most efficient catalyst of the stoichiometric two-electron reduction of BQ. PMID: 22498646
- AKR1B10 was up-regulated in association with serum alpha-fetoprotein, and was an independent risk factor for hepatocellular carcinoma in chronic hepatitis C patients. PMID: 22681639
- AKR1B10 is a unique enzyme involved in pancreatic carcinogenesis possibly via modulation of cell apoptosis and protein prenylation. PMID: 22222635
- results suggest that AKR1B10 is up-regulated by EGF and insulin through AP-1 mitogenic signalling and may be implicated in hepatocarcinogenesis PMID: 22329800
- AKR1B10 overexpression is a prominent feature in both hereditary and sporadic papillary renal cell carcinoma and is upregulated in cell lines carrying a fumarate hydratase mutation. PMID: 22014576
- AKR1B10 might promote proliferation, inhibit apoptosis and induce malignant transformation of hepatocytes by regulating the expression level of some tumor-related genes. PMID: 20943077
- Confirm prognostic value of AKR1B10 in hepatocellular carcinoma and conclude that high expression reflects less aggressive tumour behaviour. PMID: 21645211
- High AKR1B10 secretion is associated with neoplasms. PMID: 21585341
- AKR1B10 is associated with smoking and smoking-related non-small-cell lung cancer. PMID: 21672310
- the enzyme activity of AKR1B10 and AKR1B1 toward alpha, beta-unsaturated carbonyl compounds with cellular and dietary origins PMID: 21329684
- Nrf2 is one of the major factors involved in the AKR1B10 gene regulation PMID: 21277289
- overexpression and silencing of AKR1B10 decreased and increased, respectively, susceptibility to cytotoxic effects of MMC and 4-hydroxy-2-nonenal, which was formed as a product of lipid peroxidation by MMC treatment. PMID: 21317765
顯示更多
收起更多
-
亞細(xì)胞定位:Lysosome. Secreted. Note=Secreted through a lysosome-mediated non-classical pathway.
-
蛋白家族:Aldo/keto reductase family
-
組織特異性:Found in many tissues. Highly expressed in small intestine, colon and adrenal gland.
-
數(shù)據(jù)庫(kù)鏈接:
Most popular with customers
-
-
YWHAB Recombinant Monoclonal Antibody
Applications: ELISA, WB, IHC, IF, FC
Species Reactivity: Human, Mouse, Rat
-
Phospho-YAP1 (S127) Recombinant Monoclonal Antibody
Applications: ELISA, WB, IHC
Species Reactivity: Human
-
-
-
-
-